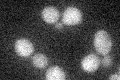
YBL088C
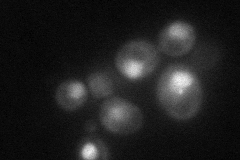
YBL088C
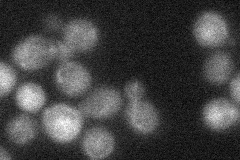
YBL088C
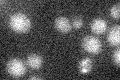
YBL088C

View description
Protein kinase primarily involved in telomere length regulation; contributes to cell cycle checkpoint control in response to DNA damage; functionally redundant with Mec1p; homolog of human ataxia telangiectasia (ATM) gene
Localization:
Intensity:
Fold change:
Significance:
-
C’ GFP library in SD
below threshold17 -
N' NOP1pr-GFP in SD
nucleus51.225 -
N' TEF2pr-mCherry in SD

nucleus23.3296 -
N' NATIVEpr-GFP in SD
punctate21.8812 -
N' TEF2pr-VC and Cyto-VN in SD

nucleus32.2098 -
C’ GFP library in SD+DTT

cytosol15.770.92No -
C’ GFP library in SD+H2O2

cytosol20.51.2No -
C’ GFP library in Starvation Media
cytosol16.260.95No -
C’ GFP library on the background of Pup2-DaMP

below threshold -
C’ GFP library on the background of CCT mutant

below threshold17.86771.05075No
